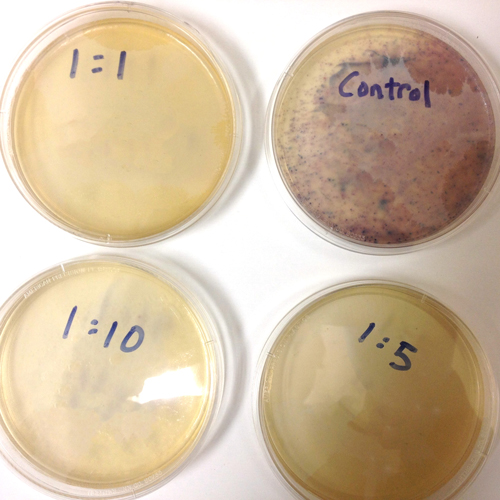
Beyond Optimum

Beyond Optimum was Founded by ChunYean Chong, a microbiologist with deep AgTech experience working with farmers in the USA with resilient plant pathogens in soil. Beyond Optimum operates in two sectors:
The worldwide agricultural sector is without an effective solution for a few soil-borne diseases where the multi-billion-dollar agrochemical companies fail. The lack of an economical/potent fungicide for plant diseases makes agriculture unsustainable to the point where the United Nations is warning of worldwide famine and the need to ensure worldwide food security.
Antibiotic resistance in poultry operation - In addition to a potential famine, the United Nations has also issued a warning about a potential bacterial pandemic due to the misuse of antibiotics in farming, with over 70% of antibiotics produced going to our farms. Historically in the pre-antibiotic eras, bacterial pandemics had always dwarfed viral pandemic. The rise of antibiotic-resistant microbes can throw the world back to the pre-antibiotic eras.
Understanding why many effective in vitro studies fail in the field, Beyond Optimum is set to produce solutions for farmers, first in Australia and later globally. The key lies in the use of seafood industry waste that were previously an environmental biohazard and potentially damaging to our waterways, specifically the waste from the oyster industry. The waste allows the company to create two products suitable for agriculture and livestock operation.